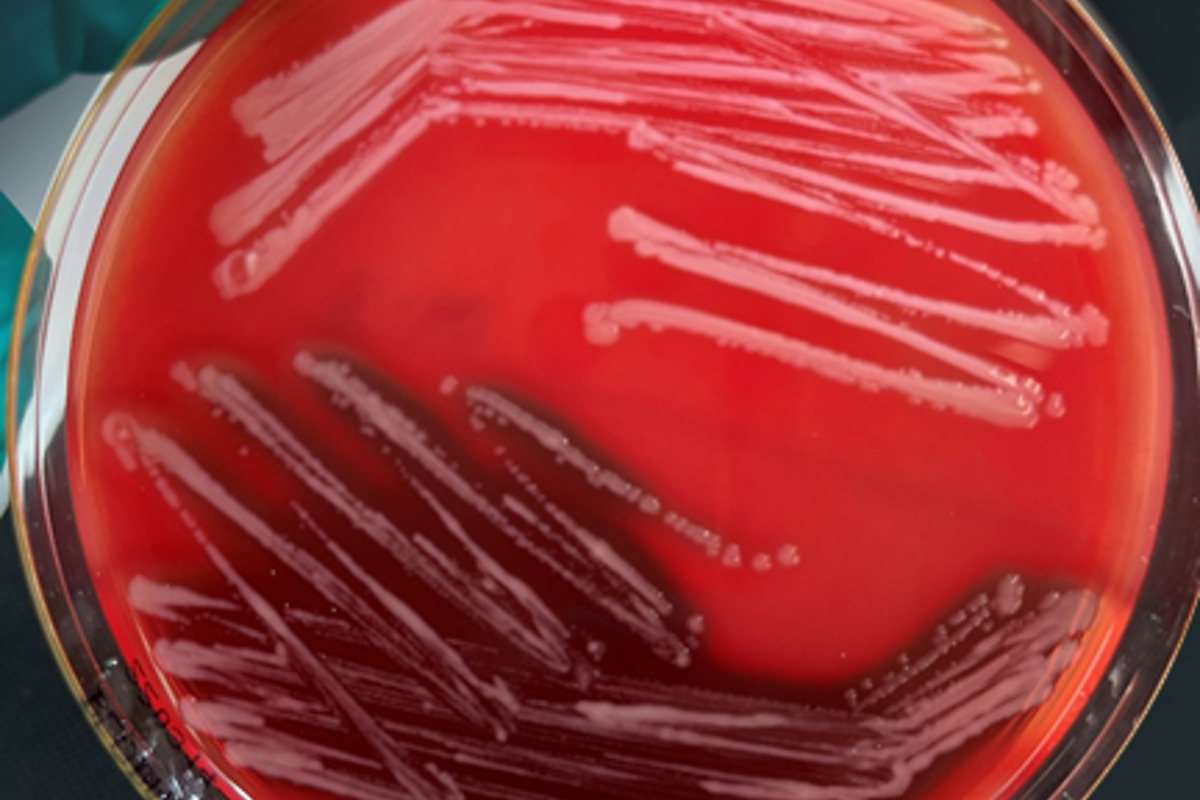

Årets vintersårsesong har vært tøff, med mange tilfeller av alvorlig sårproblematikk. Nytt fra denne sesongen, er en markant økning av en «ny» variant, en ikke-viskøs klassisk M. viscosa.
Bilde over: Utstryk av to varianter av Moritella viscosa på blodagar m/salt (BAS), øverst i bildet klassisk ikke-viskøs, og under variant type M. viscosa.
Tidligere år har variant Moritella viscosa vært dominerende, mens det i år har vært den ikke-viskøse klassiske typen som har dominert. Som følge av det kompliserte årsaksbildet, er det viktig å kartlegge hvilken type Moritella viscosa som er til stede. Vi kan gjennom våre diagnostiske metoder tilby en grundig sårutredning som differensierer mellom variant og klassisk, samt skiller mellom viskøse og ikke-viskøse isolater.

Moritella viscosa
Vintersår og Moritella viscosa har helt siden 1980-tallet vært et vanlig sykdomsproblem hos oppdrettslaks i sjø. En av bakteriens mest karakteristiske egenskaper er at den er trådtrekkende (viskøs), noe som er reflektert i tidligere navn (Vibrio viscosus) og dagens navn, M. viscosa.
Det er to hovedtyper av Moritella viscosa karakterisert ut ifra serologi og fylogeni; klassisk og variant. Disse har begge vært karakterisert ved sin klassiske tråddannelse. Tidligere var det klassisk M. viscosa som dominerte, og det er dette isolatet som er inkludert i kommersielt tilgjengelige vaksiner i dag. De siste årene har vi sett at det er variant type som dominerer ved tilbakemelding om sårutvikling og dødelighet. Dette er et isolat som skiller seg serologisk fra vaksineisolatene.
Bakgrunn
Fiskens hud, i tillegg til skjell og ytre slimlag, utgjør en viktig barriere mot det ytre miljø og beskytter fisken mot skadelige bakterier. Ved håndtering er det stor risiko for at huden skades, slim og skjell skrapes bort, og det oppstår en innfallsport for bakterier. Skånsom håndtering samt å unngå håndtering, spesielt ved fallende temperaturer, er viktig for å minimere risikoen for sårproblematikk.
Flere bakterier kan opptre i forbindelse med sår. Vinterstid har spesielt Moritella viscosa vært regnet som et viktig patogen. I tillegg kan ulike arter av Tenacibaculum spp. og vibriobakterier gi sårproblemer, enten alene eller sammen med andre patogener.
Ta gjerne kontakt med en av våre rådgivere dersom du ønsker mer informasjon om sårutredning og våre diagnostiske metoder.
PHARMAQ er verdens ledende selskap innen vaksiner og innovasjon rettet mot akvakulturnæringen og er en del av Zoetis, verdens ledende selskap innen dyrehelse. Våre innovative fiskehelseløsninger inkluderer et bredt spekter som fiskevaksiner, terapiprodukter, vaksinasjonsmaskiner inkludert servicetjenester, forskning og analyser. Selskapet leverer miljøvennlige, trygge og effektive helseprodukter til den globale akvakulturnæringen ved hjelp av målrettet forskning og engasjerte medarbeidere. Produksjon, administrasjon, forskning og utvikling ligger i Norge og med global virksomhet i kommersielle oppdrettsmarkeder har PHARMAQ rundt 375 medarbeidere. Konsernets produkter markedsføres i Europa, Nord- og Sør-Amerika samt i Asia. For mer informasjon, se selskapets hjemmeside: www.pharmaq.com. Personvernerklæring Erklæring om informasjonskapsler (cookies) Bruksvilkår
Copyright © 2020 Zoetis LLC. Alle rettigheter forbeholdt.